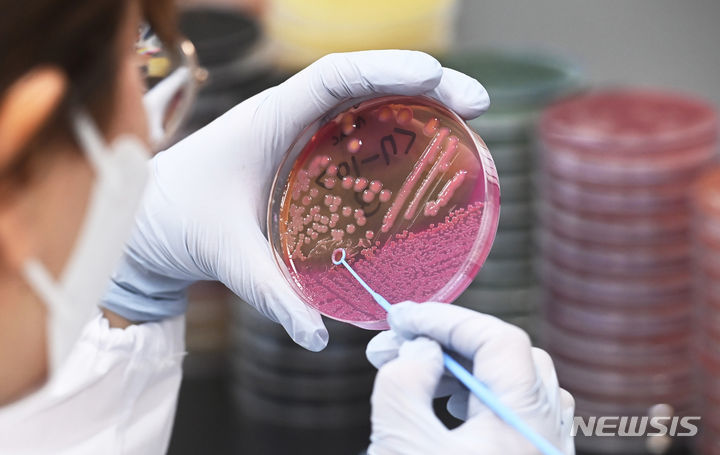

공유하기
‘찜통’ 폭염에 식중독 비상…“2시간이면 100만마리 증식”
- 뉴시스
-
입력 2023년 7월 31일 10시 38분
글자크기 설정
익히지 않는 채소에서 병원성 식중독 위험
여름철에는 겉절이 보다 볶은 김치가 안전
전국적으로 폭염이 이어지면서 병원성 대장균 식중독 발생 위험도 덩달아 커져 각별한 주의가 필요하다.
31일 식품의약품안전처 등에 따르면 최근 5년간 병원성 대장균으로 발생한 식중독 가운데 6월부터 8월까지가 전체 발생의 60%(98건·3456명)를 차지했다.
병원성 대장균은 채소류, 생고기 또는 완전히 조리되지 않은 식품이 원인이 돼 나타나는 식중독균이다. 감염되면 묽은 설사나 복통·구토·피로·탈수 등의 증상이 나타난다.
병원성 대장균 외에도 살모넬라, 캠필로박터, 퍼프린젠스, 장염비브리오 등도 여름철 식중독의 주요 원인이다. 고온 다습한 여름철에는 세균 증식이 촉진되기 때문이다.
폭염 기간 병원성 대장균 식중독을 예방하기 위해서는 채소를 올바르게 세척, 보관하는 것이 중요하다. 병원성 대장균은 덜 숙성된 퇴비나 오염된 물로 인해 재배 중 채소를 오염시킬 수 있어서다.
식약처는 “채소는 식초, 염소 소독액 등에 5분 이상 담가뒀다가 깨끗한 물로 3회 이상 세척해야 한다”며 “절단 작업은 세척 후에 해야 한다”고 설명했다.
냉장 시설이 구비 되지 않은 피서지, 캠핑장 등에서는 아이스박스 등을 준비해 보관하는 것이 좋다.
김치의 경우 여름철에는 겉절이, 열무김치 등 덜 숙성된 김치류 보다 될 수 있는 대로 익은 김치나 볶은 김치를 제공하는 것이 좋다. 병원성 대장균 식중독이 익히지 않은 채소류에서 발생할 위험이 높기 때문이다.
교차 오염에 의한 식중독 발생도 주의해야 한다. 다양한 재료를 사용하는 김밥, 주먹밥 등을 조리할 때는 칼, 도마, 그릇 등은 달걀, 고기 등을 준비하는 원재료용과 달걀지단, 시금치 무침 같은 조리된 음식용으로 구분해서 사용해야 한다.
고기를 냉장고에 보관할 때는 핏물이 흘러나오지 않도록 밀폐용기에 담아 냉장고 가장 아래 칸에 보관한다. 만약 핏물이 냉장고 내부에 묻었다면 즉시 세제와 염소 소독액을 사용해 닦는 것이 좋다. 고기에서 나온 핏물에 의해 다른 식품을 오염시킬 수 있기 때문이다.
[서울=뉴시스]
트렌드뉴스
-
1
“내가 알던 애들이 아냐” 송일국, 삼둥이 중2 폭풍 성장 근황
-
2
“내앞에 버스 세워라” 1명이 매일 민원… 못견딘 공무원 8개월 병가, 끝내 전보
-
3
“리스크 없이 과실만 챙기는 노조, 주주 자본주의 근간 흔들어”
-
4
李, 7년前 무신사 광고 언급 “사람의 탈 쓰고 이럴수 있나”
-
5
[속보]삼성전자 협상 결렬…사측 “적자사업부도 보상, 수용 불가”
-
6
권민아 “중학생 때 당한 성폭행, 18년만에 유죄 인정”
-
7
3년前 사내 유튜브에 ‘다재다능 사원’ 소개된 삼전 노조위원장 화제
-
8
삼성전자 총파업 앞두고… 성과급 한시 명문화 접근
-
9
노령연금 평균 수령액 월 70만원…11만명은 200만원 넘어
-
10
가수 별사랑, 엄마 된다…“임신 16주 차 왕자님 찾아왔어요”
-
1
“스벅 텀블러 503㎖, 박근혜 수인번호…세월호 참사일도 탱크데이”
-
2
“리스크 없이 과실만 챙기는 노조, 주주 자본주의 근간 흔들어”
-
3
삼성전자 협상 결렬…사측 “적자사업부도 보상, 수용 불가”
-
4
李, 7년前 무신사 광고 언급 “사람의 탈 쓰고 이럴수 있나”
-
5
“내앞에 버스 세워라” 1명이 매일 민원… 못견딘 공무원 8개월 병가, 끝내 전보
-
6
정청래 “후보자들 스벅 출입 자제를…5·18 조롱 처벌법 추진할 것”
-
7
하정우, 한동훈 겨냥 “정치검사 못된 버릇, 무조건 탈탈 털려 해”
-
8
[횡설수설/장원재]‘5·18 탱크 데이’라니…
-
9
삼성전자 총파업 앞두고… 성과급 한시 명문화 접근
-
10
정부 “4년내 축구장 2.4만개 규모 태양광 단지 조성”… 현실성 논란
트렌드뉴스
-
1
“내가 알던 애들이 아냐” 송일국, 삼둥이 중2 폭풍 성장 근황
-
2
“내앞에 버스 세워라” 1명이 매일 민원… 못견딘 공무원 8개월 병가, 끝내 전보
-
3
“리스크 없이 과실만 챙기는 노조, 주주 자본주의 근간 흔들어”
-
4
李, 7년前 무신사 광고 언급 “사람의 탈 쓰고 이럴수 있나”
-
5
[속보]삼성전자 협상 결렬…사측 “적자사업부도 보상, 수용 불가”
-
6
권민아 “중학생 때 당한 성폭행, 18년만에 유죄 인정”
-
7
3년前 사내 유튜브에 ‘다재다능 사원’ 소개된 삼전 노조위원장 화제
-
8
삼성전자 총파업 앞두고… 성과급 한시 명문화 접근
-
9
노령연금 평균 수령액 월 70만원…11만명은 200만원 넘어
-
10
가수 별사랑, 엄마 된다…“임신 16주 차 왕자님 찾아왔어요”
-
1
“스벅 텀블러 503㎖, 박근혜 수인번호…세월호 참사일도 탱크데이”
-
2
“리스크 없이 과실만 챙기는 노조, 주주 자본주의 근간 흔들어”
-
3
삼성전자 협상 결렬…사측 “적자사업부도 보상, 수용 불가”
-
4
李, 7년前 무신사 광고 언급 “사람의 탈 쓰고 이럴수 있나”
-
5
“내앞에 버스 세워라” 1명이 매일 민원… 못견딘 공무원 8개월 병가, 끝내 전보
-
6
정청래 “후보자들 스벅 출입 자제를…5·18 조롱 처벌법 추진할 것”
-
7
하정우, 한동훈 겨냥 “정치검사 못된 버릇, 무조건 탈탈 털려 해”
-
8
[횡설수설/장원재]‘5·18 탱크 데이’라니…
-
9
삼성전자 총파업 앞두고… 성과급 한시 명문화 접근
-
10
정부 “4년내 축구장 2.4만개 규모 태양광 단지 조성”… 현실성 논란
-
- 좋아요
- 0개
-
- 슬퍼요
- 0개
-
- 화나요
- 0개



댓글 0